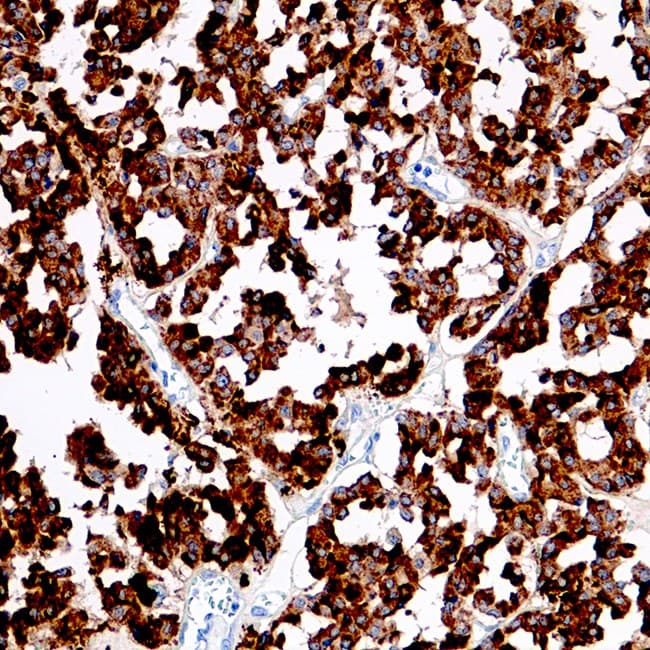

Anti-Calcitonine CE/IVD pour IHC - cytopathologie
La calcitonine est une hormone polypeptidique formée par le clivage protéolytique d'un prépropeptide plus grand. Il est produit principalement par les cellules C parafolliculaires de la thyroïde. La calcitonine est un puissant peptide abaissant le calcium plasmatique; il diminue le taux de calcium et de phosphate dans le sang en favorisant l'incorporation de ces ions dans les os. L'expression de la calcitonine se trouve dans l'hyperplasie des cellules C et les carcinomes médullaires de la thyroïde. C'est un marqueur utile dans l'identification des anomalies de prolifération des cellules C et dans la distinction du carcinome médullaire du cancer papillaire et du cancer de la thyroïde folliculaire.
D'autres tissus tels que les poumons et le tractus intestinal peuvent également synthétiser de la calcitonine. L'expression de la calcitonine dans les cellules neuroendocrines non néoplasiques et néoplasiques de ces organes, telles que les carcinoïdes et les carcinomes du poumon à petites cellules, peut être observée.

Coupe de carcinome médullaire de la thyroïde
Coupe de carcinome médullaire de la thyroïde
Résultat de votre recherche : 16 produit(s) trouvé(s)
Affinez votre recherche :
RUOCE / IVD
- Unconjugated 13
- human 13
- Primary antibody
- rabbit 10
- mouse 3
- IHC 16
- Polyclonal 5
- SP17 5
- IHC521 3
- IHC699 3
Référence
Description
Cond.
Prix HT
‹
›



